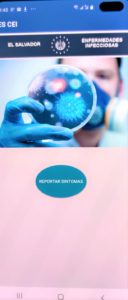

TIP Line 3.0 App
Please note the NEW address to download the “TIP Line” app! Download Application in Google Playstore: https://www.instapaykey.com/AAI/appstore.html
The new TIP Line 3.0 App enables real-time anonymized reporting on human trafficking. The Control panel is distributed to law enforcement agencies and airport managers to both report and monitor responses in addition to, most importantly, sharing data. This is the first universal platform that can be shared among government agencies for real-time intelligence gathering to combat human trafficking.
You will note that the former app started with a https://www.lslsandbox address. The “lslsandbox” is a typical address for app developers. Keeping it in a “sandbox” enabled us to make the suggested agency changes in a coded format as AAI worked through the global law enforcement agency requirements of INTERPOL, UNODC, INL, TSA, SELEC, and Migracion here in El Salvador. The “sandbox” format, had a narrower “bandwidth” than required concurrent law enforcement operations in all areas of the world and could not handle the volume of thousands of investigative requests per day. We now have a dedicated server that meets the security and oversight control of the financial industry, where FDIC, NIST, and several relevant federal agencies make on-site security inspections of our server and the donor’s operations. AAI’s New Jersey server site, owned by Logica Corporation. Logica’s server site meets the stringent demands that international law enforcement demands.
Many thanks to our development donor, Logica (www.logica.com), who recently merged with CGI. The Logica staff, under the guidance of their CEO Steve Farah, have spent many months in lab and agency headquarters with law enforcement authorities to make sure that AAI’s new reporting tool meets their needs and will readily be used by global, regional and municipal law enforcement.
Here are the new links for the AAI TIP Line 3.0 application:
Download Application in Google Playstore: https://www.instapaykey.com/AAI/appstore.html (unfortunately we do not have iPhone availability at this tihis time)
How does “TIP Line” 3.0 work? 




- TIP Line allows you to provide intuitive information relevant to the reporting needs of law enforcement. It provides this information anonymously. Pictures and video are recommended, and is very useful for any prosecution potential, but is not necessary.
- TIP Line does not store reported media on your device. Government prosecutors can thus prove that any submitted media was not altered. Your report proves that your device was within 10 ft. of the site of a potential crime, at a precise date and time that cannot be altered and disputed by defendants.
- Media goes directly to an automatically designated law enforcement Command Center. Sometimes this number is a national emergency number, but TIP Line will usually automatically deliver the tip to the closest commercial airport operations security anywhere in the world at virtually any airport under the management of ICAO’s 193 Member Countries. The location indicators are those used by air traffic control in those Member Countries. These location indicators are then matched to the email address and phone number of the nearest airport operations security. If you submit your report from home, for example, the app will automatically tell you how far one of these airports is from your device, but the report will be submitted to that airport operations security depicted on your screen.
- Worried about local corruption? TIP Line’s Command Center is overseen by many airports and law enforcement agencies. These officials will be seeing your report in real-time with one another. If your report is not acted upon within 5 minutes, a red light blinking next to your report will alert others to get a detailed status report. This status report will also be logged into the Command Center as a follow up on the specific incident until it is properly vetted through policies and procedures. It is thus easier for investigators to both access and share all available information about each report, all in one tidy window.
-
El Salvador CoVID-19 App
I am pleased to inform you that AAI, having completed the “TIP Line” human trafficking reporting app, has added an infectious disease component on the control panel to assist El Salvador as it fights against the COVID-19 pandemic. AAI has been assisted by Logica Laboratories (www.logicalabs.com) in New Jersey, INL (US International Narcotics Law Enforcement) Northern Triangle, Migracion El Salvador and the Health Ministry of El Salvador to make this possible.
Feel free to download the Android version at

https://www.lslsandbox.com/escei.apk
We look forward to deploy this app more widely in our missions and welcome any input
David Rivard, AAI Board of Directors
sridave@aol.com
